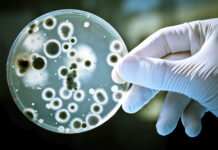

യുഎസ്സില് അഞ്ചാംപനി പടരുന്നതായി റിപ്പോർട്ട്. സെന്റര് ഫോര് ഡിസീസ് കണ്ട്രോളിന്റെ ഒടുവിലത്തെ കണക്കനുസരിച്ച് 21 സംസ്ഥാനങ്ങളിലും ന്യൂയോര്ക്ക് നഗരത്തിലുമായി 607 പേര്ക്കാണ് ഈ രോഗം സ്ഥിരീകരിച്ചത്. രോഗബാധിതരായവരില് ഭൂരിഭാഗവും കുട്ടികളാണ്. 2024-ല് യുഎസ്സിലെ ആകെ അഞ്ചാംപനി ബാധിതരുടെ എണ്ണം 285 ആയിരുന്നു. ആകെ രോഗികളില് 196 പേര് 5 വയസിന് താഴെ പ്രായമുള്ള കുട്ടികളാണ്. 5നും 19-നും ഇടയില് പ്രായമുള്ള 240 രോഗികളിൽ 20 വയസിനുമേല് പ്രായമുള്ള 159 രോഗികളും പ്രായം ലഭ്യമല്ലാത്ത 12 രോഗികളുമാണ് ഉള്ളത്. രോഗം ബാധിച്ച 2കുട്ടികള് ടെക്സാസില് മരിച്ചു. 21 സംസ്ഥാനങ്ങളിലെ 22 ഇടങ്ങളാണ് സിഡിസിയുടെ കണക്ക് പ്രകാരം ‘മീസില്സ് ഹോട്ട്സ്പോട്ടുകള്’. നിലവില് രോഗം ബാധിച്ചവരില് 74 പേരാണ് ആശുപത്രികളിൽ ചികിത്സ തേടുന്നത്. ഇതില് 42 പേര് 5 വയസില് താഴെ പ്രായമുള്ളവരും 19 പേര് അഞ്ചിനും 19-നും ഇടയില് പ്രായമുള്ളവരുമാണ്. യുഎസ്സിലെ യുവഡോക്ടര്മാരില് പലരും ആദ്യമായാണ് അഞ്ചാംപനി ബാധിച്ചവരെ കാണുന്നതെന്ന് മാധ്യമങ്ങൾ റിപ്പോര്ട്ട് ചെയ്യുന്നു. മെഡിക്കല് ടെക്സ്റ്റ് ബുക്കുകളിലും പരീക്ഷാ പേപ്പറുകളിലും മാത്രമാണ് ഇവര് അഞ്ചാംപനിയെ പരിചയപ്പെട്ടത്. ജീവിതത്തില് ഒരിക്കലും കാണേണ്ടി വരില്ല എന്ന് കരുതിയ രോഗത്തെയാണ് ഇപ്പോള് നേരിടുന്നതെന്ന് ഡോക്ടര്മാര് വ്യക്തമാക്കി.